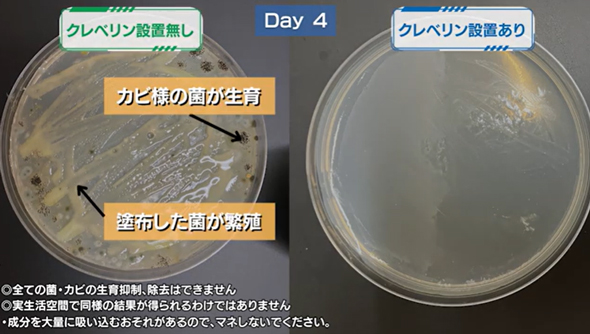

「空間除菌」批判のあとに何が起きたか 二酸化塩素業界の次の一手:スピン経済の歩き方(3/6 ページ)
かつて「クレベリンショック」と呼ばれた空間除菌批判から数年。二酸化塩素を使う製品はいま、消費者庁の厳しい基準のもとで“正攻法”の再起を図っている。信頼回復への道のりは……。
効果を発揮する場所
サイト内のQ&Aでも詳しく解説しているが、クレベリンの二酸化塩素分子が、特定の浮遊または付着したウイルスや菌に対して除去機能を持ち、特定の悪臭成分に対して消臭機能を持つことは、さまざまな試験で証明されている。
ただし、それらは全て「密閉空間」で行われているものなのだ。
一般的な生活空間で「密閉」された状況はあまりない。窓を閉め切った室内であっても、人の出入りによるドアの開閉で自然に換気が行われてしまう。消費者からは「実際の生活空間でも試せばいいのに」という声もあるが、それを再現するのは難しい。
例えば「6畳相当の部屋」を再現しようと思っても、実際の生活空間では、窓や扉の場所、家具の大きさや数など何万通りも考えられる。さらには、人がどれくらい出入りするかなど条件も無数にある。これをすべて再現して試験をおこなうことはほぼ不可能なのだ。
つまり、空間除菌製品がうたう「機能」は、あくまで「密閉空間」という試験条件下で得られたものだ。だったら、パッケージにも広告にも「密閉ありき」の説明をしないってのは消費者を勘違いさせてしまうでしょ――というのが、消費者庁側のロジックなのだ。
もちろん、役所とケンカをしてもロクなことにならない。クレベリン側もその点を全面的に受け入れていることは、公式YouTubeチャンネルで公開している動画「【実験】クレベリン 置き型の菌・カビの生育抑制作用」からも分かる。
これは12Lのアクリル密閉容器内に浴室内の壁で採取した菌を入れ、1つはクレベリンの置き型1カ月用を設置、もう1つには何も置かずに4日後に比較した実験だ。クレベリンがないほうのシャーレはカビだらけになったが、クレベリンを設置したほうはきれいなままだった。
動画内では、実験の開始前や結果発表後にも繰り返し「全ての菌・カビの生育・抑制はできません」「実生活空間で同様の結果が得られるわけではありません」というテロップがそれなりの大きさで入っているのだ。
Copyright © ITmedia, Inc. All Rights Reserved.
関連記事
なぜ“怪しい”のに売れている? リカバリーウェアという不思議なヒット商品
リカバリーウェアが売れている。本当に効果があるのかビミョーなところだが、それでもヒットし続けるワケとは――。
「男性用のレース下着」なぜ人気なのか ワコールが販売して分かったこと
ワコールの男性下着ブランド「ワコールメン」から発売された「レースボクサー」の勢いが止まらない。なぜ多くの男性から支持を得ているのか。